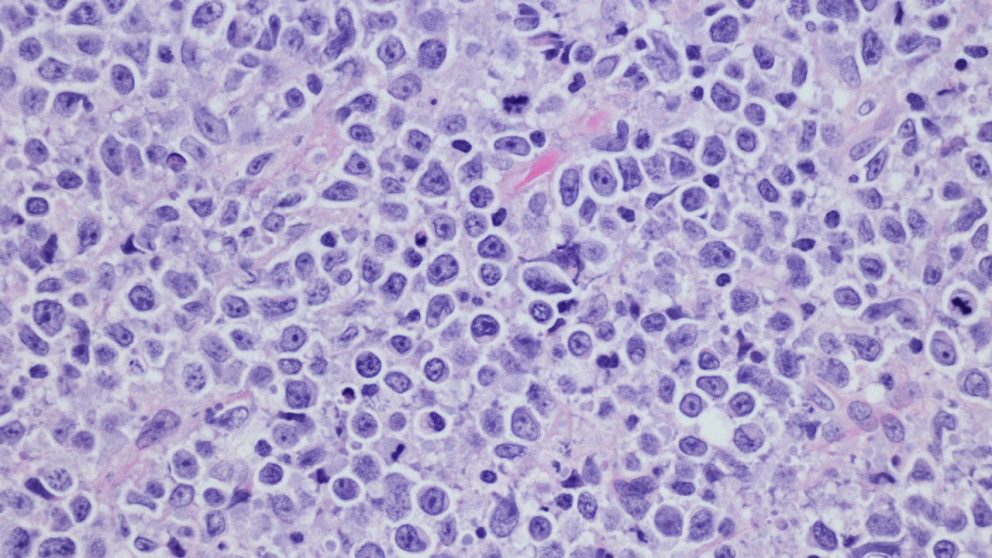

- Largest study of its kind provides new insights on lymphoma biology to guide clinical approaches
- Researchers identified three subgroups with differential benefit from CD19 CAR T cell therapy
- Study points to opportunities for alternative approaches to treat patients who do not benefit from CAR T cell therapies
HOUSTON, JUNE 18, 2025 ― In the largest study of its kind, researchers from The University of Texas MD Anderson Cancer Center identified three subgroups of patients with large B-cell lymphoma (LBCL) who have different levels of benefit from CD19 chimeric antigen receptor (CAR) T cell therapy.
In the study, published today in Cancer Cell, researchers profiled samples from 232 patients with LBCL to create "LymphoMAPs" that provide detailed information about the environment surrounding lymphoma cells and how they relate to clinical data and patient outcomes. The findings offer new insights to guide physicians toward the best potential clinical pathways for patients based on the underlying biology of the tumors profiled.
"This study marks a pivotal step in refining precision medicine for patients with large B-cell lymphoma by accounting for the non-malignant cells that surround and interact with the malignant B-cells," said corresponding author Michael Green, Ph.D., associate professor of Lymphoma/Myeloma. "By identifying the three patient subgroups that have significantly different outcomes following CD19 CAR T cell therapy, we move toward enhancing treatment selection for clinicians and pave the way for biology-driven targeted therapies for patients who may not respond as well."
CAR T cell therapy is a type of immunotherapy that uses a patient's own T cells, which are genetically engineered to express CAR molecules that specifically target and eliminate cancer cells. There are three CAR T cell therapies approved for patients with LBCL, and these have had promising results for many patients. However, less than half of patients have long-lasting responses to CAR T cell therapies, highlighting a need to understand the factors that influence outcomes.
In this study, researchers profiled single cells from 232 biopsy samples from 217 newly diagnosed and previously treated lymphoma patients. In total, researchers profiled over 1.8 million cells, which is approximately 10 times more than the previous largest study of lymphoma.
To validate these findings, researchers integrated the data with published results from the ZUMA-7 Phase III clinical trial, which examined the effectiveness of axicabtagene ciloleucel (axi-cel), a CAR T cell therapy, compared to the standard-of-care therapy in patients with relapsed/refractory diffuse large B-cell lymphoma. Through this work, the researchers identified three primary types of lymphoma microenvironments in patients with LBCL that have different patterns of response to CAR T cell therapy:
- The fibroblast/macrophage group consists of patients with tumors that are depleted of T cells and contain a high abundance of cancer-associated fibroblasts. These patients have mixed responses when treated with CAR T cell therapy, but as a group still significantly benefit compared to chemotherapy.
- The lymph node group consists of patients with tumors that have many T cells supported by non-hematopoietic cells normally found within lymph nodes that support T cell health. These patients have the greatest benefit from CAR T cell therapy.
- The T cell exhausted group consists of patients with tumors that have mostly CD8 exhausted T-cells and activated macrophages. Researchers found these patients had no significant benefit from CAR T cell therapy and therefore are in need of alternative therapeutic options. Researchers believe there are opportunities to target key biological pathways of these tumors to improve outcomes.
"The underlying biology clearly supports the association with CAR T cell outcomes and highlights opportunities for interventions using targeted therapies that are either already in the clinic or in the late stages of preclinical development," Green said. "These insights bring us closer to optimizing therapies for all patients, ensuring more effective, individualized care."
Using insights from this study, MD Anderson researchers plan to collaborate with other academic cancer centers and pharmaceutical companies to advance clinical trials focused on targeted therapies for patients in subgroups with poorer outcomes.
The research was funded by a generous philanthropic contribution from Beatriz and Ed Schweitzer and by the MD Anderson Lymphoid Malignancies Program. A complete list of collaborating authors and their disclosures can be found here.